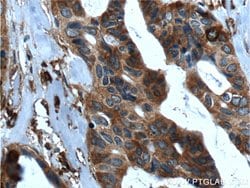
SRMS Rabbit anti-Human, Polyclonal, Proteintech 20 &mu;L; Unconjugated:Antibodies,

missing translation for 'onlineSavingsMsg'
Learn More
Learn More
SRMS Rabbit anti-Human, Polyclonal, Proteintech
Rabbit Polyclonal Antibody
Brand: Proteintech 26447-1-AP-20UL
This item is not returnable.
View return policy
Description
Protein kinases are enzymes that transfer a phosphate group from a phosphate donor, generally the g phosphate of ATP, onto an acceptor amino acid in a substrate protein. By this basic mechanism, protein kinases mediate most of the signal transduction in eukaryotic cells, regulating cellular metabolism, transcription, cell cycle progression, cytoskeletal rearrangement and cell movement, apoptosis, and differentiation. With more than 500 gene products, the protein kinase family is one of the largest families of proteins in eukaryotes. The family has been classified in 8 major groups based on sequence comparison of their tyrosine (PTK) or serine/threonine (STK) kinase catalytic domains. The STE group (homologs of yeast Sterile 7, 11, 20 kinases) consists of 50 kinases related to the mitogen-activated protein kinase (MAPK) cascade families (Ste7/MAP2K, Ste11/MAP3K, and Ste20/MAP4K). MAP kinase cascades, consisting of a MAPK and one or more upstream regulatory kinases (MAPKKs) have been best characterized in the yeast pheromone response pathway. Pheromones bind to Ste cell surface receptors and activate yeast MAPK pathway.Specifications
| SRMS | |
| Polyclonal | |
| Unconjugated | |
| SRMS | |
| C20orf148, SRM, SRMS, Tyrosine protein kinase Srms | |
| Rabbit | |
| Antigen Affinity Chromatography | |
| RUO | |
| 6725 | |
| -20°C | |
| Liquid |
| Immunoprecipitation, Immunohistochemistry (Paraffin) | |
| 0.43 mg/mL | |
| PBS with 50% glycerol and 0.1% sodium azide; pH 7.3 | |
| Q9H3Y6 | |
| SRMS | |
| SRMS Fusion Protein Ag24062 | |
| 20 μL | |
| Primary | |
| Human | |
| Antibody | |
| IgG |
Product Content Correction
Your input is important to us. Please complete this form to provide feedback related to the content on this product.
Product Title
Spot an opportunity for improvement?Share a Content Correction